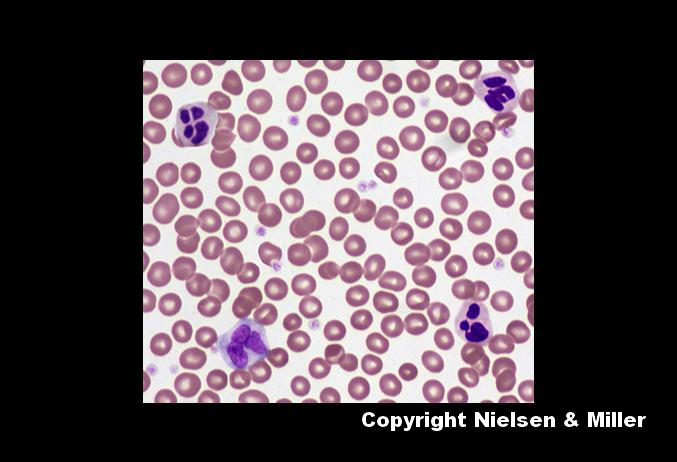

|
Java Games: Flashcards, matching, concentration, and word search. |
 |
 |
| A | B |
 | adipose-connective-tissue-heart,  |
 | adrenal gland,  |
 | apocrine-gland-section, .jpg) |
 | areolar-connective-tissue, .jpg) |
 | arteriole-cross-section, .jpg) |
 | artery-cross-section, .jpg) |
 | bladder,  |
| blood-smear,  |
 | compact_bone-femoral,  |
 | cross-section-of-artery_and_vein,  |
 | dense-irregular-connective_tissue, .jpg) |
 | dense-regular-connective_tissue, .jpg) |
 | elastic-cartilage, .jpg) |
 | elastic-connective-tissue, .jpg) |
 | epididymis-cross-section, .jpg) |
 | esophagus, .jpg) |
 | vas-deferens-cross-section, .jpg) |
 | uterine-tube-cross-section,  |
 | striated-cardiac-muscle,  |
 | pseudostratified-columnar_epithelium,  |
|
| |